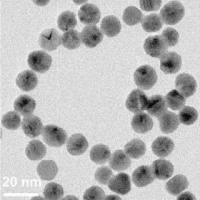
粒酶活性检测实验

上海研谨生物科技有限公司
9 年
手机商铺
商家活跃:
产品热度:
- NaN
- 0
- 0
- 2
- 2
全部产品
- 查看全部分类
- 技术服务
- 常用生化试剂
- sigma(部分现货促销)
- 标准品/对照品
- 酶联免疫试剂盒
- 生化试剂盒
- 免疫组化及常用抗体
- 抗体
- 细胞生物学
- 淋巴细胞分离液
- 进口血清(Gibco血清/Hyclone血清/BI血清/Genimi血清/PAA血清/PAN血清)
- Axygen试剂盒及相关耗材
- 脂质体2000(转染试剂)(原装)
- 弗氏不完全佐剂、弗氏完全佐剂
- 牛血清白蛋白(BSA)
- CCK-8试剂盒
- 蛋白酶K
- 常用实验耗材
- Axygen
- Corning
- PALL
- Amresco
- KIRGEN
- 乳品(牛奶﹑羊奶﹑奶粉)检测产品
- 水产品(鱼﹑虾﹑蟹)检测产品
- 畜禽(组织﹑尿样﹑血清)检测产品
- 蜂蜜检测产品
- 饲料﹑谷物类检测产品
- 动物疫病类检测产品
- 常用电泳缓冲液
- 分子生物常用试剂及试剂盒
- 核酸纯化
- PCR及RT-PCR相关产品
- DNA分子量标准
- 克隆载体及相关产品
- 感受态细胞
- 蛋白质研究相关产品
- 电泳相关产品
- 转染相关产品
- 即用型试剂
- 德国WAK品牌
- 各类产品快速检测试剂盒系列